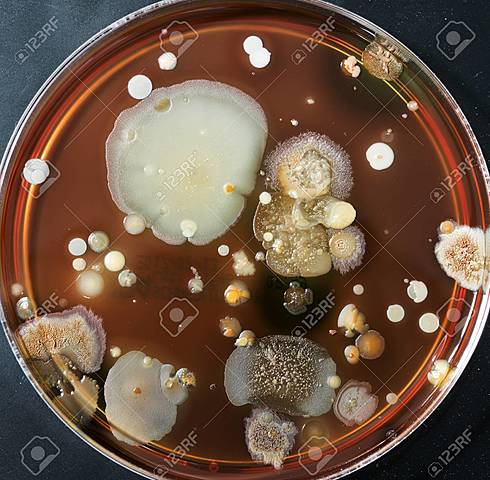
1769 (dc)

-
Aunque los microorganismos se originaron hace aproximadamente 4.000 millones de años, la microbiología es relativamente una ciencia joven. Los primeros microorganismos se observaron hace 300 años y sin embargo pasaron unos 200 años hasta que se reconoció su importancia. http://webcd.usal.es/Web/educativo/micro2/tema01.html
-
El óptico holandés Zacarías Janssen junto a su padre, Hans Lippershey, inventa el microscopio a finales del siglo XVI. Otra versión considera que fue Galileo quien lo inventó en 1629 y fue el primero en utilizar esta palabra. ttps://www.curiosfera.com/quien-invento-microscopio-historia/
-
El científico Ingles Robert Hooke fue quien mejoró el microscopio observando cortes de corcho muy delgados hechos con una navaja, lo que lleva el descubrimiento de las células y microscopio compuesto https://prezi.com/f8ciee_vb9p1/linea-de-tiempo-de-la-microbiologia/
-
La primera persona en describir los microorganismos en detalle fue el holandés Antony van Leeuwenhoek en 1684, a los cuales denominó animáculos. Leeuwenhoek examinó el agua de lluvia, de mar, de río, saliva y otras materias. http://webcd.usal.es/Web/educativo/micro2/tema01.html
-
En 1745 John Needham hirvió trozos de carne para destruir los organismos preexistentes y los colocó en un recipiente abierto. Al cabo de un tiempo observó colonias de microorganismos sobre la superficie y concluyó que se generaban espontáneamente a partir de la carne. http://webcd.usal.es/Web/educativo/micro2/tema01.html
-
En 1769, Lazzaro Spallanzani repitió el experimento pero tapando los recipientes, no apareciendo las colonias, lo que contradecía la teoría de la generación espontánea. Pero Needham argumentó que el aire era esencial para la vida incluída la generación espontánea de microorganismos y este aire había sido excluido en los experimentos de Spallanzani. http://webcd.usal.es/Web/educativo/micro2/tema01.html
-
Eduar Jenner, crea la vacuna contra la viruela, realiza la primera vacunación en este año, después de descubrir la inoculación con la viruela proporciona inmunidad
https://prezi.com/f8ciee_vb9p1/linea-de-tiempo-de-la-microbiologia/ -
Franz Schulze pasó el aire a través de unas soluciones ácidas fuertes hacia el interior de un recipiente con carne hervida. Al año siguiente Theodor Schwann pasó el aire a través de tubos calientes. Los microorganismos no aparecían habían sido aniquilados. Sin embargo, los que apoyaban la generación espontánea comentaban que el ácido y el calor alteraban el aire de tal manera que impedía la generación espontánea de los microorganismos.
-
Joseph Lister el padre de la cirugía asptetica, introduce la eliminación de microbios de la piel por medio del uso de anticepticos, recomendaba operar bajo el vaporizador de fenol como agente desinfectante https://prezi.com/f8ciee_vb9p1/linea-de-tiempo-de-la-microbiologia/
-
Louis Pasteur demuestra que no existe la generación espontanea y que los seres vivos provienen de oros seres vivos https://prezi.com/f8ciee_vb9p1/linea-de-tiempo-de-la-microbiologia/
-
Friederich Miescher, descubre el ADN a través de experimentos del pus en las bandas quirúrgica donde aisló moléculas ricas en fosfato que llamo ácidos nucleicos https://prezi.com/f8ciee_vb9p1/linea-de-tiempo-de-la-microbiologia/
-
Martenius Beinjerinck, denomino el virus como partículas infecciosas las cuales producen enfermedad https://prezi.com/f8ciee_vb9p1/linea-de-tiempo-de-la-microbiologia/
-
Frederick griffth,lleva a cabo el descubrimiento de ransformación bacteriana
-
Frits Zernike desarrolla un microscopio de contraste de fases que permite ver a microorganismos vivos
-
Wendell Mederith Stanley, consigue cristalizar el virus del mosaico del tabaco
-
Oswald Avery, Colin Macleod y Martyn Maccarty, demuestran que el ADN es material genetico
-
Barry Marshal y Robin Warren demuestran el papel de la bacteria helicobacter pylori en la boca del estomago
-
se descubre la bacteria gigante Thiomargarita namibiensis
-
En 1769, Lazzaro Spallanzani repitió el experimento pero tapando los recipientes, no apareciendo las colonias, lo que contradecía la teoría de la generación espontánea. Pero Needham argumentó que el aire era esencial para la vida incluída la generación espontánea de microorganismos y este aire había sido excluido en los experimentos de Spallanzani. http://webcd.usal.es/Web/educativo/micro2/tema01.html